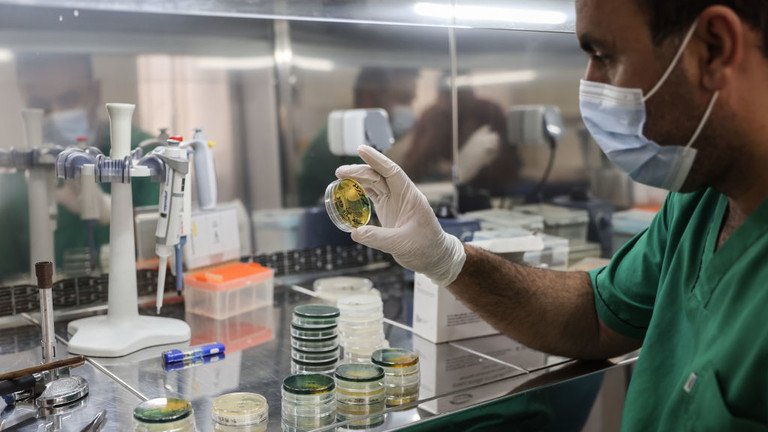

Numri i rasteve të kolerës në Siri po rritet ndjeshëm pasi shpërthimi ka infektuar tashmë mijëra njerëz në të gjithë vendin, ka njoftuar Caritas International.
Në një deklaratë për shtyp të mërkurën, organizata me bazë në Gjermani tha se ishte ‘jashtëzakonisht e shqetësuar’ për këtë gjë, duke vënë në dukje se shpërthimi ishte ‘shumë i pazakontë në Lindjen e Mesme dhe në Siri’ dhe ishte një simptomë e qartë e ‘ngjarjeve katastrofike’ në vend.
“Varfëria që është rritur prej vitesh dhe kushtet e këqija higjienike, në të cilat refugjatët dhe personat e zhvendosur në veçanti duhet të jetojnë, janë terreni mbi të cilin po përhapet tani kjo sëmundje tipike e varfërisë.” – paralajmëroi, Christoph Klitsch-Ott, një zyrtar i Karitasit.
Sipas ‘Caritas’, të paktën 13,059 njerëz në Siri janë infektuar me këtë sëmundje që nga fillimi i shtatorit, dhe mbi 60 persona kanë vdekur zyrtarisht nga simptomat kryesore të kolerës, diarreja e të vjella. Besohet se rezervuarët e ujit të pijshëm të ndotur dhe perimet e ndotura janë fajtorët kryesorë të shpërthimit.
Caritas vëren se 12 vitet e fundit të luftës në Siri kanë dëmtuar rëndë infrastrukturën sanitare të vendit, pasi rreth 13 milionë njerëz aktualisht nuk kanë qasje në ujë të pastër dhe objekte sanitare. Vihet re se situata është veçanërisht shkatërruese në kampet e refugjatëve, ku njerëzit janë të detyruar të jetojnë në hapësira të mbyllura dhe kanë qasje të kufizuar në burimet e ujit të sigurt.
Ndërsa organizata jofitimprurëse ka bërë përpjekje për të shpërndarë ujë të pijshëm të pastër dhe dezinfektues në zonat e prekura rëndë të vendit, ka frikë se sëmundja mund të vazhdojë të përhapet, jo vetëm brenda Sirisë, por në të gjithë Lindjen e Mesme, sipas Klitsch-Ott.
Muajin e kaluar, Organizata Botërore e Shëndetësisë paralajmëroi gjithashtu për shpërthime të kolerës në rreth 26 vende të botës, duke deklaruar se shkalla mesatare e vdekshmërisë këtë vit ishte tre herë më e lartë krahasuar me pesë vitet e mëparshme.
Drejtuesi i ekipit të OBSH-së për kolerën dhe sëmundjet epidemike të diarresë, Philippe Barboza, u bëri thirrje vendeve që ‘të veprojnë tani’ për të parandaluar përhapjen e sëmundjes edhe më tej, dhe për të gjetur mënyra për të prodhuar më shumë vaksina kundër kolerës dhe për të zgjeruar qasjen ndaj antibiotikëve dhe ujit të pastër.
Kolera është një sëmundje akute diarreike e shkaktuar nga infeksioni bakterial i zorrëve. Njerëzit priren të kapin sëmundjen kur gëlltisin ushqim ose ujë të kontaminuar me bakteret e kolerës.
Infeksioni besohet se prek miliona njerëz në mbarë botën çdo vit, por, në shumicën e rasteve, simptomat janë të lehta ose nuk ekzistojnë. Megjithatë, nëse nuk trajtohet, sëmundja mund të bëhet shpejt kërcënuese për jetën, veçanërisht për të moshuarit, si dhe për njerëzit që vuajnë nga dehidratimi.